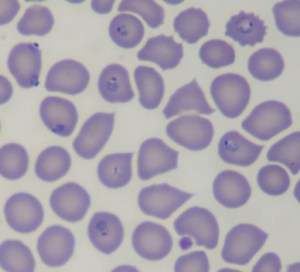
Blood film of the man on a missionary trip to Gambia

Clinical Vignette 14
A straightforward case for the Christmas week – Merry Christmas and Happy 2015, by the way!
This young man returned from Gambia 2 weeks ago, and started having high fever for 5 days prior to seeking medical attention. He had been on a missionary trip, helping to build schools and houses in rural villages in Gambia. Whereas he had been offered malaria prophylaxis, he had not been particularly compliant to the weekly mefloquine regimen. His blood film is shown below.
Question: What is the treatment for his condition?
[Updated 3rd January 2015]
The blood film shows the typical ring forms of Plasmodium falciparum. The CDC website has an excellent section describing the different blood film appearances of the various human malaria parasites. It is important to initiate treatment quickly, as falciparum malaria can be rapidly fatal. The World Health Organization (WHO) has an updated monograph on the treatment of malaria that can be downloaded free from its website. Patients with severe malaria should be managed as inpatients, in a unit where close monitoring can be performed (i.e. high dependency or intensive care unit) if possible. Severe malaria is defined by the presence of one of more of the following:
- Abnormal bleeding (including haemoglobinuria and severe anaemia)
- Clinical jaundice and evidence of other organ dysfunction
- Impaired consciousness
- Multiple convulsions (>2 within the past 24 hours)
- Circulatory collapse or shock
- High parasite load (>2.5% parasitemia in low transmission areas or >20% in any setting)
- High serum lactate
- Hypoglycemia
- Metabolic acidosis
- Pulmonary oedema
- Renal impairment
Treatment with antimalarials for severe malaria include intravenous (IV) artesunate, with rectal artesunate given in areas where IV access is limited, or IV quinine in when artesunate is not available. A second drug (doxycycline, mefloquine, etc.) is generally given to prevent the development of resistance. In most countries where artesunate is available, oral (or rectal) formulations are generally combinations with another anti-malarial drug.